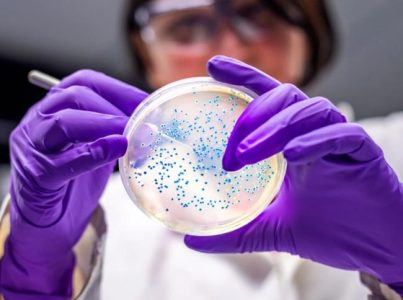

一個“全副武裝”的惡性病原體幾乎能躲避所有藥物的攻擊,以及一種致死率高達60%的真菌,領銜加拿大聯邦衛生官員最新公布的最具威脅的病原體名單。
這份更新後的“高影響力”超級病原體清單,列出了能讓人嚴重患病甚至致命的病原體,其中包括導致大腸桿菌和沙門氏菌感染的細菌家族,以及極度耐藥的淋病菌。
總計29種病原體進入觀察名單,最初有68種被公共衛生局專家工作組和顧問團列入候選。最終入選的病原體依據可治療性、傳播力、致死率,以及對弱勢群體的影響來評分和排名。
這是自 2015 年發布初始名單以來的首次更新。十年來出現了新的威脅,包括耐藥真菌耳念珠菌(Candida auris),它在醫院內傳播,可引發血液、心臟、神經系統和器官感染;以及生殖支原體(Mycoplasma genitalium),一種性傳播感染。
已知病原體的耐藥性也在上升,包括肺炎鏈球菌,這種嚴重感染可導致致命的腦膜炎、肺炎或敗血症,尤其威脅兒童和老人。
抗藥性加劇 危及加拿大醫療體系
“病原體觀察名單反映了加拿大的現實情況。”麥克馬斯特大學生物化學和生物醫學教授格里·賴特(Gerry Wright)說。
由於沒有新藥問世,“未來我們會看到越來越多的人因為抗生素無效而長期住院甚至死亡。”賴特警告說。
抗微生物耐藥性是全球重大健康威脅之一。當細菌、病毒、真菌和寄生蟲感染無法被抗生素、抗病毒藥和其他藥物遏制時,疾病治療難度增加,傳播、重症和死亡風險升高。據估計,僅 2018 年就有約 14,000 人死亡。
四級優先排序 高危名單揭曉
加拿大的“病原體優先級清單”將病原體分為四級,從高優先到低優先。
最高優先級病原體包括:
耐碳青黴烯類腸桿菌科細菌(Enterobacterales)
* 常見於人體腸道,但能引發泌尿道、腹部和血流感染。
* 傳播途徑包括人與人接觸(髒手、傷口、糞便)或被污染的醫療器械。
* 碳青黴烯類抗生素是“青黴素高速路的最後一站”,一旦耐藥,治療選擇幾乎為零。
高度耐藥的淋病菌
* 這種性傳播感染幾乎對所有現有抗生素免疫。
* 2022年,加拿大淋病發病率是30年前的三倍,為30年來最高。
* 發病率最高的人群是20至39歲的男性,以及15至30歲的女性。
* 它與旅行相關的性接觸有關,並增加HIV感染風險。
* 如果無法治療,可能導致盆腔炎或不孕不育。

耐碳青黴烯類銅綠假單胞菌(Pseudomonas)
* 被賴特稱為“超級壞菌”,幾乎對所有抗生素無動於衷。
* 能引發肺炎,尤其對囊性纖維化患者危害嚴重。
* 喜歡潮濕環境,如肺部黏液。賴特實驗室正致力於研發針對它的藥物。
耐藥鮑曼不動桿菌(Acinetobacter)
* 能附着在輸液袋、輸液杆、透析管等醫療設備上,引發血液和傷口感染。
耳念珠菌(Candida auris)
* 一種新近出現的致命真菌,可通過針頭、導管侵入皮膚,殘留在醫院水槽、床欄和窗簾上。
* 對免疫力低下人群尤其危險,死亡率在30%至60%之間。
* 它未被列入2015年舊名單,如今被認為是關鍵公共衛生威脅。
製藥行業冷淡 專家呼籲預防
該名單依賴2017至2022年的數據,存在滯後。專家建議每三至五年更新一次,而非十年一次。
微生物能在數小時內快速進化。但與上世紀80年代不同,如今極少有製藥公司願意研發抗生素。“抗生素治癒疾病,而大藥企更喜歡治療慢性病,這樣能保證長期收益。”賴特解釋說。
賴特實驗室最近在《自然》雜誌發表研究,稱從技術員後院土壤樣本中分離出一種蛋白質,在小鼠實驗中對幾乎所有名單上的病原體都有活性。他正在嘗試將其開發為候選藥物。

但這需要時間和巨額資金。加拿大抗微生物耐藥工作組醫學顧問坎查納·阿瑪拉通加(Kanchana Amaratunga)提醒:“無論帶來什麼新藥,耐藥性最終都是不可避免的。”
她與賴特都強調,防範才是關鍵,包括合理使用抗生素、加強監測、早期檢測和疫苗接種。
數據顯示,加拿大侵襲性肺炎鏈球菌疾病病例在2021至2022年間激增82%,其中近68%的病例由可通過疫苗預防的菌株引起。

